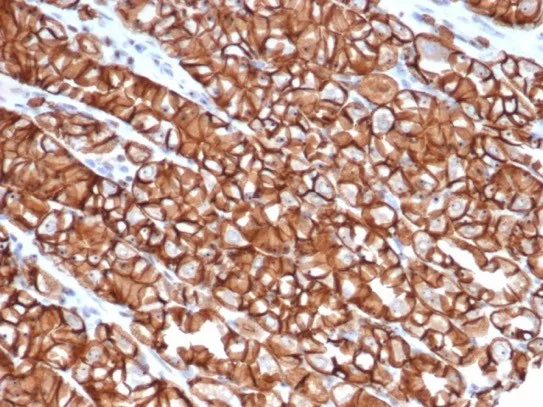

Formalin-fixed, paraffin-embedded human colon stained with E-Cadherin Recombinant Mouse Monoclonal Antibody (rCDH1/6769). Inset: PBS instead of primary antibody; secondary only negative control.
IHC analysis of formalin-fixed, paraffin-embedded human stomach. Stained using rCDH1/6769 at 2ug/ml in PBS for 30min RT. HIER: Tris/EDTA, pH9.0, 45min. 2°C: HRP-polymer, 30min. DAB, 5min.
E-cadherin is a transmembrane, calcium dependent cell adhesion protein that mediates cell to cell adhesion and maintains structural and functional integrity of epithelial tissues. It also has pivotal barrier functions and maintains the polarity of epithelial cells. Reduced or aberrant E-cadherin expression breaks cell to cell contacts, and thus, cells acquire the ability to migrate. In normal tissues, immunostaining of E-cadherin is localized to the membrane of epithelial cells, consistent with its role in cell adhesion. And in tumor tissues, E-cadherin stains positively in glandular epithelium as well as adenocarcinomas of the lung, gastrointestinal tract, and ovary. It has also been shown to be positive in some thyroid carcinomas. A combination of E-cadherin and p120 catenin may help distinguish ductal carcinoma of the breast from lobular carcinoma. And also, several studies have reported that reduced E-cadherin expression is correlated with poor prognosis in several types of carcinomas.
There are no reviews yet.